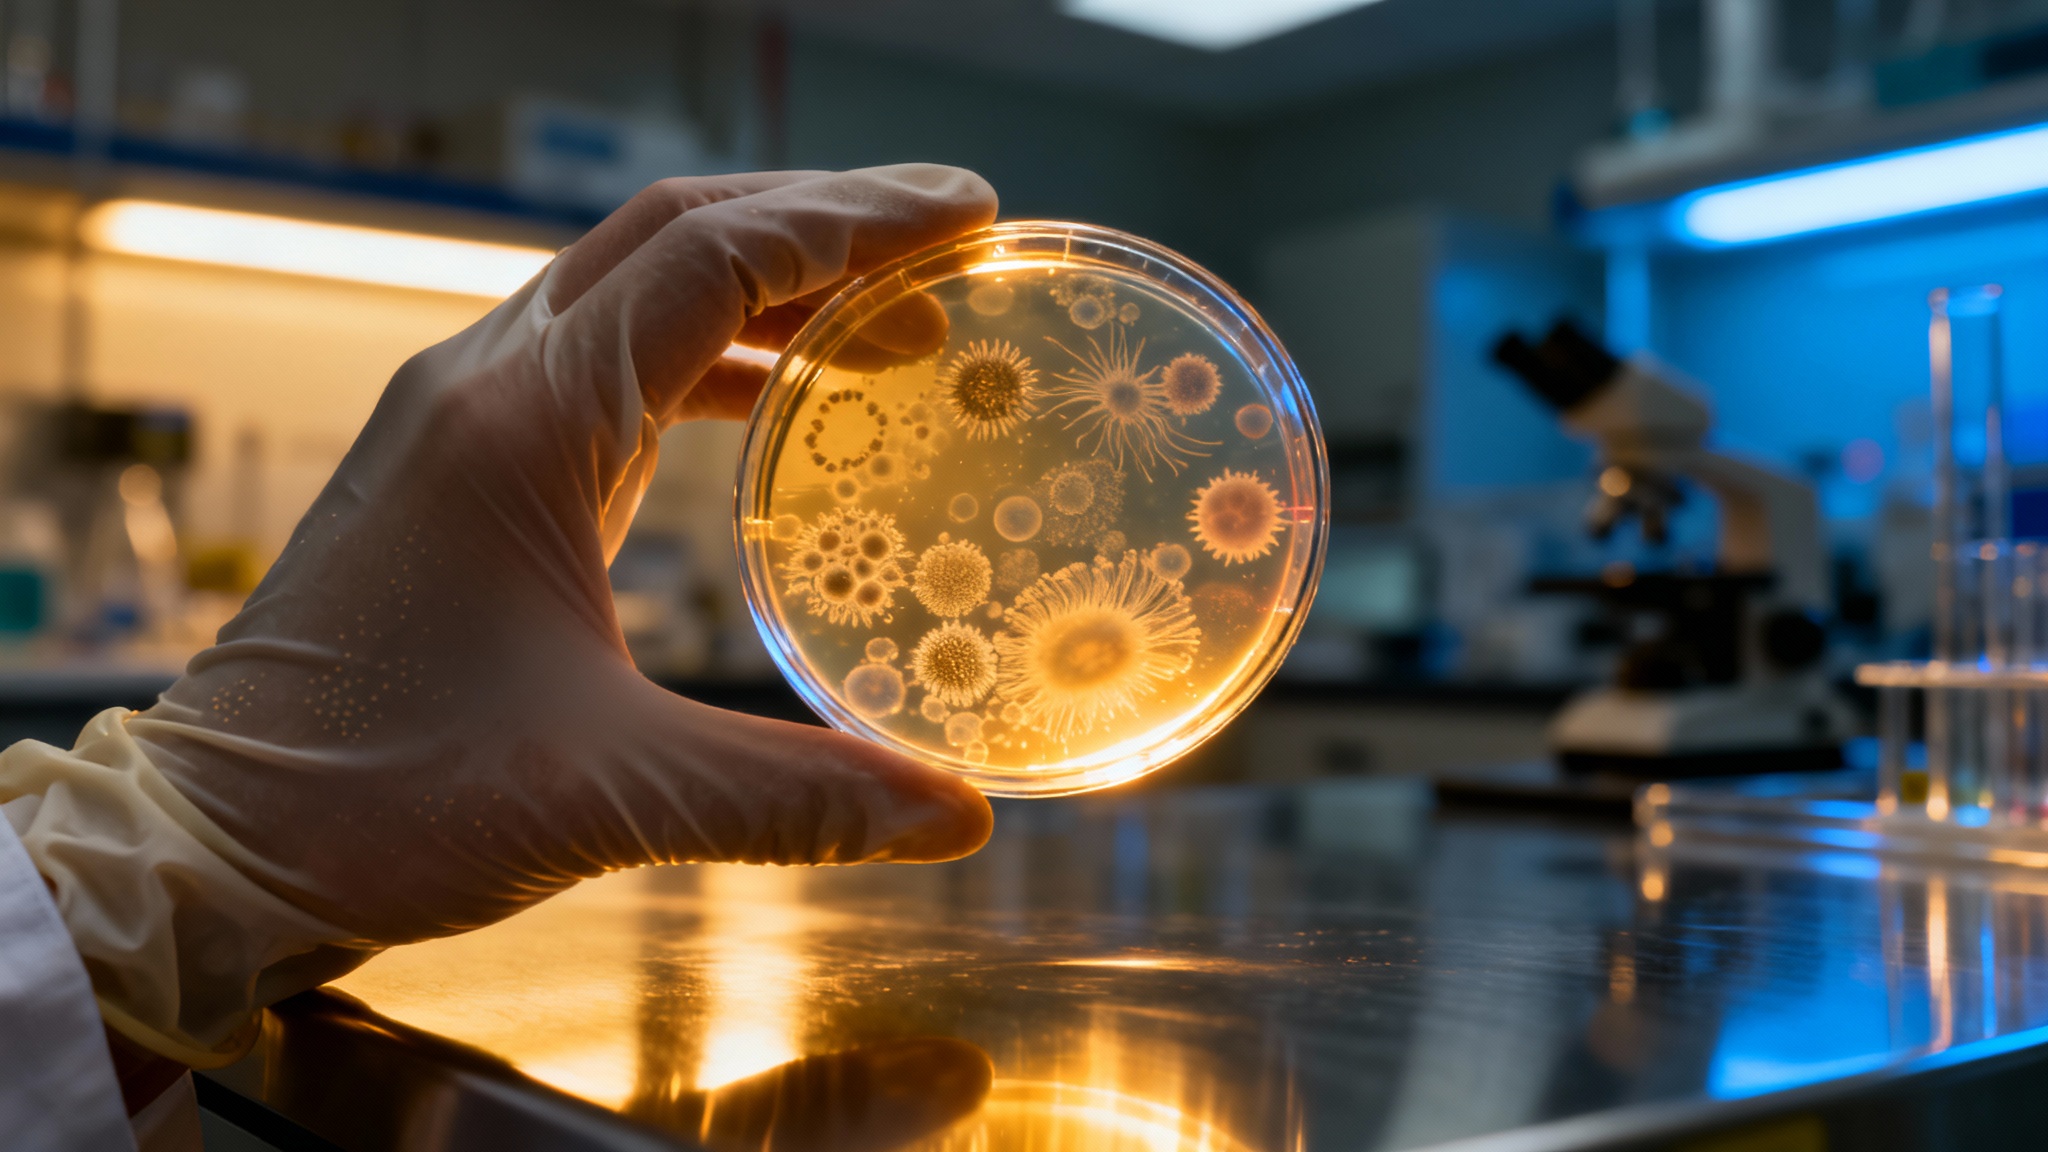

Des “vers zombies” vieux de 24 000 ans ressuscités par des scientifiques russes
Auteur: Mathieu Gagnon
Pas de panique, ce n’est pas un film d’horreur
Je sais ce que vous vous dites en lisant le titre. On a tous vu assez de films catastrophe pour savoir que réveiller des trucs congelés depuis la nuit des temps, c’est rarement une bonne idée. Mais respirez un grand coup, promis, ce n’est pas aussi sinistre que ça en a l’air. Des chercheurs russes ont effectivement ramené à la vie et cloné des organismes « zombies » vieux de 24 000 ans, mais… ce n’est pas exactement une situation à la Walking Dead.
De quoi parle-t-on exactement ? Les morts-vivants en question sont des rotifères bdelloïdes. C’est un nom un peu barbare, je vous l’accorde, pour désigner des animaux microscopiques qu’on appelle aussi « animaux à roues » à cause de leur bouche circulaire entourée de petits poils. Franchement, ils sont presque mignons si on les regarde de près. Un peu comme les tardigrades – ces oursons d’eau indestructibles que tout le monde adore – les rotifères sont des extrêmophiles. Ça veut dire quoi ? Simplement qu’ils peuvent supporter des conditions totalement dingues, comme la chaleur étouffante des sources sous-marines ou même… le vide spatial. Rien que ça.
Un voyage dans le temps au cœur de la Sibérie

Pour réaliser cette petite prouesse, les scientifiques ne sont pas allés chercher bien loin… enfin, si, en fait. Ils se sont rendus en Sibérie pour découper une tranche de pergélisol. Vous savez, ce sol qui reste gelé en permanence, hiver comme été. La zone spécifique où ils ont creusé est figée dans la glace depuis au moins la fin de l’époque du Pléistocène. Pour vous donner une idée de l’échelle de temps, on parle d’une période située quelque part entre 2,6 millions d’années et 11 700 ans en arrière. C’est vertigineux, non ?
Ils ont dû creuser assez profondément, jusqu’à environ 3,5 mètres (soit 11,5 pieds, pour être précis), pour extraire un échantillon de sol intact. La datation au carbone a confirmé l’âge incroyable de ces échantillons : environ 24 000 ans. Une fois les rotifères congelés récupérés, les chercheurs les ont dégelés doucement. Et là, surprise ! Les petites bêtes ont tout simplement recommencé à vivre leur vie, comme si de rien n’était. Elles se sont même mises à se reproduire de manière asexuée. Le secret de cette résurrection ? Un état d’animation suspendue appelé cryptobiose.
Stas Malavin, l’auteur principal de l’étude et chercheur à l’Institut des problèmes physico-chimiques et biologiques de la science du sol en Russie – oui, c’est un nom à rallonge, je sais – a expliqué le phénomène à Live Science. En gros, ces organismes suspendent leur métabolisme et accumulent certains composés, comme des « protéines chaperonnes », qui les aident à récupérer quand les conditions s’améliorent. C’est fascinant parce que ce n’est pas juste une sieste accidentelle ; c’est une préparation biologique complexe, un peu comme un ours qui prépare son hibernation, mais en version microscopique et millénaire.
Des clones, de la cryobiologie et l’avenir

L’expérience a pris une tournure presque comique à un moment donné. Après avoir laissé le sol dégeler avec un milieu spécial pour aider au réveil, les scientifiques ont rapidement perdu le fil. Impossible de distinguer les créatures microscopiques vieilles de 24 000 ans de leurs nouveaux descendants ! Pourquoi ? Parce que les rotifères se reproduisent en créant des clones exacts d’eux-mêmes. On se retrouve donc avec des vers microscopiques tout neufs qui sortent des photocopies d’eux-mêmes à la chaîne.
Mais au-delà de l’anecdote, étudier la cryptobiose chez ces bestioles permet de faire avancer le domaine de la cryobiologie, l’étude des êtres vivants à très basse température. Stas Malavin suggère même que cela pourrait, hypothétiquement, mener à des technologies similaires pour les humains. Mais ne réservez pas tout de suite votre caisson cryogénique ! C’est une idée encore extrêmement lointaine. Nous sommes, disons… décidément plus complexes que de minuscules rotifères ou d’autres organismes extrêmophiles.
Ces rotifères rejoignent une liste assez prestigieuse d’organismes « ressuscités » après avoir été congelés, qui comprend déjà de la mousse, des mauvaises herbes et de petits vers appelés nématodes. Chacun a été ramené à la vie après au moins 1 000 ans de calme glacé. À l’avenir, comprendre comment des plantes plus résistantes utilisent ces propriétés cryptobiotiques pourrait tout changer, du stockage alimentaire à l’agriculture, et peut-être même accompagner les humains dans un voyage vers Mars.
Conclusion : Une petite victoire pour la vie

Alors voilà, pour l’instant, nous n’avons que quelques vers microscopiques flambant neufs qui font tourner la photocopieuse biologique à plein régime. Mais quand on y réfléchit bien, c’est quand même sacrément cool, non ? Cela nous rappelle la ténacité de la vie, capable de mettre pause pendant des millénaires pour mieux repartir.
Je suppose que cela nous donne aussi une petite leçon d’humilité face à la nature. Ces petites choses étaient là bien avant nous, et elles seront probablement encore là bien après.
Ce contenu a été créé avec l’aide de l’IA.